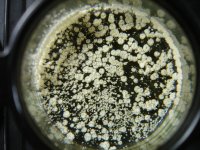
DSC00596.JPG

-
Members of the previous forum can retrieve their temporary password here, (login and check your PM).
You are using an out of date browser. It may not display this or other websites correctly.
You should upgrade or use an alternative browser.
You should upgrade or use an alternative browser.
DMT Extraction from ///acacia bark...
- Thread starter 1Starway7
- Start date
I'm not sure exactly what your purpose is with sharing those images, but since you did, I have to point out the fact that I'm seeing open flames and naptha in what appears to be rather close proximity, which is a very dangerous thing to do, as explained in the Extraction Safety Guidelines (point 8, to be specific).
Be careful and mindful while doing extractions. Safety always first!

Be careful and mindful while doing extractions. Safety always first!


Apologies if I came off too harsh, I just felt it's going to be a tad bit confusing (especially to a beginner) to have 40 photos in no particular order without any explanation on what photo applies to which step of the tek you're referring to. It's also a bit unclear what's next to open flame and what isn't, and I feel one can never go wrong being too cautious.
Your right...saftey is best!Apologies if I came off too harsh, I just felt it's going to be a tad bit confusing (especially to a beginner) to have 40 photos in no particular order without any explanation on what photo applies to which step of the tek you're referring to. It's also a bit unclear what's next to open flame and what isn't, and I feel one can never go wrong being too cautious.

Here are more photos of the extraction.... larger crystals... .... and not even half way through the 200G bark extraction!...
.....MAGNAFY PICTURES SEE CRYSTAL STRUCTURE!
.after all night in freezer....instead of doing defat... taking short cut....i simply pour off most of the napatha that contains most of fats and some dmt......into another jar ...and place crystals in front of computer fan and quickly evaporate most of Napatha ...
Then....to make product cleaner.... i let the crystals dry even longer.... for a few days... to get rid of any trace napatha left in the product...
Images .... copied from another site....
Attachments
Last edited:
What kind of Acacia bark did you use? Looking 
I missed the picture with the open flame, but in case you didn’t know, you can just get a saucepan of already boiled water and place a glass vessel with your naptha into that to heat it. Or you can just let the heat from your freshly added lye do most of the work. Should be no need to have solvent anywhere near a flame during extraction.

I missed the picture with the open flame, but in case you didn’t know, you can just get a saucepan of already boiled water and place a glass vessel with your naptha into that to heat it. Or you can just let the heat from your freshly added lye do most of the work. Should be no need to have solvent anywhere near a flame during extraction.
My acacia bark came from the big island..[hawaii]..was .very low fat by the way!What kind of Acacia bark did you use? Looking
I missed the picture with the open flame, but in case you didn’t know, you can just get a saucepan of already boiled water and place a glass vessel with your naptha into that to heat it. Or you can just let the heat from your freshly added lye do most of the work. Should be no need to have solvent anywhere near a flame during extraction.

There was... NO... napatha at all....! near my flame..i was only heating up bark soup..//.and water later.... used as a hot water bath with added salt for increased ...ionic strength...
.I learned to extract some years back from the old DMT nexus...starway6

Last edited:
This pull of crystals after ... freeze percpitation... looks a little crowded posibly because of smaller glass dish?
I admit i did take a short cut by just.... pouring off the napatha//// after removing from freezer..... into another jar...[ thinking?... i poured off most of the plant fats that way?
then quickly fan evaporating any remaining trace of napatha causing crystal blooming formations...
After drying more over night it smelled clean with a nice sweet tryptomine smell..
But if you look close .....or....[ magnafy the picture]..... you should see smaller white particles mostly grouped together that did not have the flower bloom formations...
Ealyier when doing extraction.....I know i waited long enough for the napatha pull to seperate from the soup ... ...and that should have kept the lye in the water below where it belongs...
It smells clean...But what could the smaller white particles that arent appearing to form similar crystal formations be?
I doubt that the smaller grouped particles are lye...They shouldent be...because i was patient waiting long enough for the napatha to seperate...
Maybe the smaller grouped particles are just harmless stuff that got through the extraction...since i didnt do a proper .....de fat?
Should i re crystalize the works again to get rid of the [grouped smaller white particles?]
Any opinion appreciated....! photos taken through a magnafying glass...
Could the smaller [grouped particles] be dmt that just didnt crystalize? or some harmless part of the bark extract/...i doubt its lye? opinions welcome!
please magnify and look at the smaller white particles /compaired to the full crystals...could they be crystals that just didnt compleatly form because the dish was too small/?
I admit i did take a short cut by just.... pouring off the napatha//// after removing from freezer..... into another jar...[ thinking?... i poured off most of the plant fats that way?
then quickly fan evaporating any remaining trace of napatha causing crystal blooming formations...
After drying more over night it smelled clean with a nice sweet tryptomine smell..
But if you look close .....or....[ magnafy the picture]..... you should see smaller white particles mostly grouped together that did not have the flower bloom formations...
Ealyier when doing extraction.....I know i waited long enough for the napatha pull to seperate from the soup ... ...and that should have kept the lye in the water below where it belongs...
It smells clean...But what could the smaller white particles that arent appearing to form similar crystal formations be?
I doubt that the smaller grouped particles are lye...They shouldent be...because i was patient waiting long enough for the napatha to seperate...
Maybe the smaller grouped particles are just harmless stuff that got through the extraction...since i didnt do a proper .....de fat?
Should i re crystalize the works again to get rid of the [grouped smaller white particles?]
Any opinion appreciated....! photos taken through a magnafying glass...
Could the smaller [grouped particles] be dmt that just didnt crystalize? or some harmless part of the bark extract/...i doubt its lye? opinions welcome!
please magnify and look at the smaller white particles /compaired to the full crystals...could they be crystals that just didnt compleatly form because the dish was too small/?
Attachments
Last edited:
Found more molecule in bottom of extraction jar i didnt expect to find..This pull of crystals after ... freeze percpitation... looks a little crowded posibly because of smaller glass dish?
I admit i did take a short cut by just.... pouring off the napatha//// after removing from freezer..... into another jar...[ thinking?... i poured off most of the plant fats that way?
then quickly fan evaporating any remaining trace of napatha causing crystal blooming formations...
After drying more over night it smelled clean with a nice sweet tryptomine smell..
But if you look close .....or....[ magnafy the picture]..... you should see smaller white particles mostly grouped together that did not have the flower bloom formations...
Ealyier when doing extraction.....I know i waited long enough for the napatha pull to seperate from the soup ... ...and that should have kept the lye in the water below where it belongs...
It smells clean...But what could the smaller white particles that arent appearing to form similar crystal formations be?
I doubt that the smaller grouped particles are lye...They shouldent be...because i was patient waiting long enough for the napatha to seperate...
Maybe the smaller grouped particles are just harmless stuff that got through the extraction...since i didnt do a proper .....de fat?
Should i re crystalize the works again to get rid of the [grouped smaller white particles?]
Any opinion appreciated....! photos taken through a magnafying glass...
Could the smaller [grouped particles] be dmt that just didnt crystalize? or some harmless part of the bark extract/...i doubt its lye? opinions welcome!
please magnify and look at the smaller white particles /compaired to the full crystals...could they be crystals that just didnt compleatly form because the dish was too small/?
It appears as chunky crystals.....some are becoming snow crystal like as it drys more... please magnafy images...
Attachments
store your dmt in tincture dropper bottle ..the most convenient way i know....Found more molecule in bottom of extraction jar i didnt expect to find..
It appears as chunky crystals.....some are becoming snow crystal like as it drys more... please magnafy images...

In photos below easily storing over 2 grams of molecule..and should keep for years...
can apply drops to herbs...or vaporize in electronic vaporizer...just evaporate the alcohol first...
Attachments
Last edited:
Does it keep better in IPA?store your dmt in tincture dropper bottle ..the most convenient way i know....
In photos below easily storing over 2 grams of molecule..and should keep for years...
can apply drops to herbs...or vaporize in electronic vaporizer...just evaporate the alcohol first...
I dont know for shure? .... IPA has a lot of water in .....if you mean .like 70 percent rubbing alcohol//or 90 percent alcohol? i would not use rubbing alcohol..Does it keep better in IPA?
Im using 190 proof Everclear....95 percent by volume......because its very pure alcohol .
You might get away with using very high proof.... CLEAR VODKA...as long as the percentage of water is VERY LOW/...
OK. 190 is no problem. Does it keep better without oxidation kept that way?I dont know for shure? .... IPA has a lot of water in .....if you mean .like 70 percent rubbing alcohol//or 90 percent alcohol? i would not use rubbing alcohol..
Im using 190 proof Everclear....95 percent by volume......because its very pure alcohol .
You might get away with using very high proof.... CLEAR VODKA...as long as the percentage of water is VERY LOW/...
I know that if you keep dmt to long in crystal or wax form in a dish ...in open air... over time it will oxidize some but still the molecule will work...OK. 190 is no problem. Does it keep better without oxidation kept that way?
While suspended in alcohol ... it really doesnt change much...
When you dose ..so many drops of tincture onto a three layer fine screen .... you wait for the alcohol to evaporate.... then the dmt is in a light yellow waxy form..... embeded in the chamber screen for vaping....
oxidation ... just changes the way it looks a little......but doesnt harm the molecule at all... i will still send you on a ride...

read this post below....about low profile dmt storage...may explaine it better...
different ways..including low profile storage!

photos below...more than two grams of molecule... [crystals] ..... easily desolved and stored in small... one ounce 30 ml tincture bottle]....using high proof alcohol / 190 proof everclear...
very convenient! ... [low profile].... will keep for months or years...can be droppered onto anything organic....... [or for vaping...used with 3 or more... very fine layers of Stainless steel ..[vandy vape..ss316l mesh.....[.as top screen layers].. ...[to avoid drip down] ... as the molecule drys.... ... it fuses onto the fine screen layers... for vaping later]... ....fine screens sit on top of a slightly thicker stiffer...[coarser]..[ base screen...] .. base screen is a normal chamber pipe screen... then product embedded in finer top screen layers,,, allowing alcohol to evaporate first before vaping...../let sit for a few hours... or better over night.... to a week for cleaner product...
store in dark tincture bottle//in cool darks closet/// or in refrigerator... cant think of any way more storable or convienent! ...info taken from old nexus site..
The pictures of tincture below has a light yellow color because it was not compleatly ...de fated... the product instead ..[ a napatha pour off before drying the crystals instead]........ its only some ...plant fats in it no harm...
If some one was to compleatly ....de fat ...the product the tincture may look more clear!
My Acacia bark ...grows wild in... ..Hawaii.......I dont think its native to the....big island.... but its been there for many years... !Do you mean an Acacia species native to there, or an introduced species?
O
Off topic but good to see you around again @wira !Do you mean an Acacia species native to there, or an introduced species?
Hi acacian, I hadn't gone anywhere, still checking in regularly but have rarely felt like I needed to chime in. It has been a while since I posted!
bobfromearth, I understand if you want to keep it secret, but if not (and if it is common) are you willing to share any description or photos of the species you're working with?
bobfromearth, I understand if you want to keep it secret, but if not (and if it is common) are you willing to share any description or photos of the species you're working with?
Surely is confusa?
Similar threads
- Replies
- 2
- Views
- 161
- Replies
- 8
- Views
- 73
- Replies
- 1
- Views
- 655
- Replies
- 6
- Views
- 1K